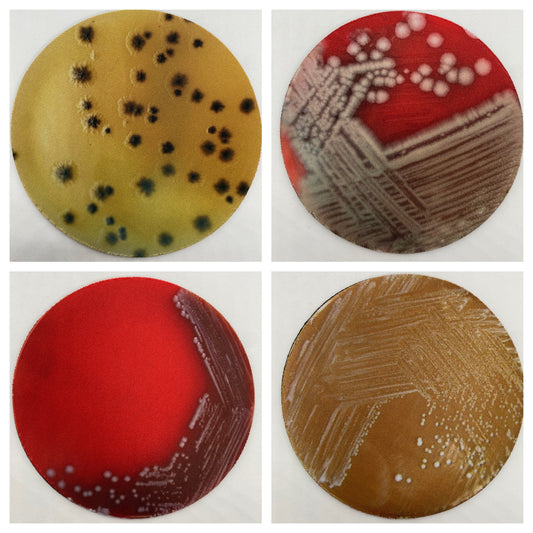

-
Bacterial Pathogen Neoprene Coasters - Bacteria, Petri Dish | Fun Gift for Microbiologists, Infectious Disease, Teachers, Lab Techs
Regular price $12.00 USDRegular priceUnit price perSale price $12.00 USD

-
North American Birds of Prey Tumbler, Cup | 20oz Skinny Tumbler | Funny Gift for Wildlife Lover, Falconer, Educator
Regular price $24.99 USDRegular priceUnit price perSale price $24.99 USD

-
Vultures of the World Cup | 20oz Skinny Tumbler | Gift for Wildlife Lover, Falconer, Educator, Over the Hill Gift
Regular price $24.99 USDRegular priceUnit price perSale price $24.99 USD

-
Vulture Facts Tumbler, Cup | 20oz Skinny Tumbler | Gift for Wildlife Lover, Falconer, Educator, Over the Hill Gift
Regular price $24.99 USDRegular priceUnit price perSale price $24.99 USD

-
Spin Instructor Quotes | 20oz Skinny Tumbler | Inspirational Gift for Cyclists, Fitness Friends, Peloton Fans
Regular price $24.99 USDRegular priceUnit price perSale price $24.99 USD

-
Cardiology Cardiac EKG ACLS | 20oz Skinny Tumbler | Fun Gift for Nurses, Cardiologists, Medical Students, Electrophysiologists
Regular price $24.99 USDRegular priceUnit price perSale price $24.99 USD

-
Cardiology Cardiac EKG ACLS | 30oz Skinny Tumbler | Fun Gift for Nurses, Cardiologists, Medical Students, Electrophysiologists
Regular price $30.99 USDRegular priceUnit price perSale price $30.99 USD

-
Personalized Dentistry Tooth Oral Surgeon | 20oz Skinny Tumbler | Fun Gift for Dentists, Oral Hygienist, Dental Students
Regular price $25.99 USDRegular priceUnit price perSale price $25.99 USD
-
Neurons Firing, Neurology | 20oz Skinny Tumbler | Fun Gift for Neurologists, Neurosurgeon, Neuroscientist, Researcher, Geniuses
Regular price $24.99 USDRegular priceUnit price perSale price $24.99 USD

-
Neuron Neoprene Coasters | Fun Gift for Neurologists, Neurosurgeon, Neuroscientist, Researcher, Geniuses
Regular price $12.00 USDRegular priceUnit price perSale price $12.00 USD

-
Personalized Skeletal Anatomy | 20oz Skinny Tumbler | Fun Gift for Chiropractor, Physiatrist, Physical Therapist
Regular price $25.99 USDRegular priceUnit price perSale price $25.99 USD
-
Personalized Neurobiology Brain Anatomy | 20oz Skinny Tumbler | Fun Gift for Neurobiologist, Psychiatrist, Geniuses, Neurodivergent
Regular price $24.99 USDRegular priceUnit price perSale price $24.99 USD
-
Microbiology Puns | 20oz Skinny Tumbler | Fun Gift for Microbiologists, Infectious Disease Professionals, Teachers
Regular price $24.99 USDRegular priceUnit price perSale price $24.99 USD

-
Personalized Cardiology Cardiac EKG ACLS | 30oz Skinny Tumbler | Fun Gift for Nurses, Cardiologists, Medical Students, Electrophysiologists
Regular price $34.99 USDRegular priceUnit price perSale price $34.99 USD

-
Cardiology Cardiac EKG ACLS | 20oz Pink Glitter Skinny Tumbler | Fun Gift for Nurses, Cardiologists, Medical Students, Electrophysiologists
Regular price $27.99 USDRegular priceUnit price perSale price $27.99 USD

-
Bacterial Pathogen Neoprene Coasters - Terrible Pathogen, Petri Dish | Fun Gift for Microbiologists, Infectious Disease, Teachers, Lab Techs
Regular price $12.00 USDRegular priceUnit price perSale price $12.00 USD